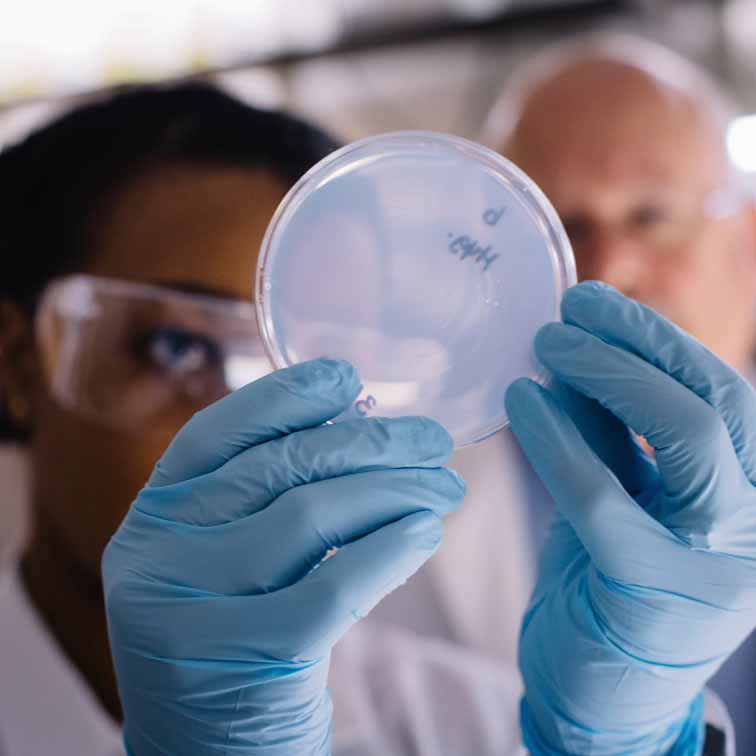
two scientists examining experiment

History
First caretakers of the land
Honoring Indigenous Peoples
In fall 2021, the Emory Board of Trustees approved a Land Acknowledgment for Emory University recognizing the Muscogee (Creek) and other Indigenous nations expelled in the years before Emory’s founding. The work of Emory leaders, historians, and experts across the university, the statement builds upon years of work by students, faculty, and staff to recognize the legacy of Native American and Indigenous dispossession on the lands of Emory’s campuses.

“This statement is about accountability as much as it is about understanding our past. And my hope is that it will inspire powerful conversations on our campuses as well as action and engagement.”